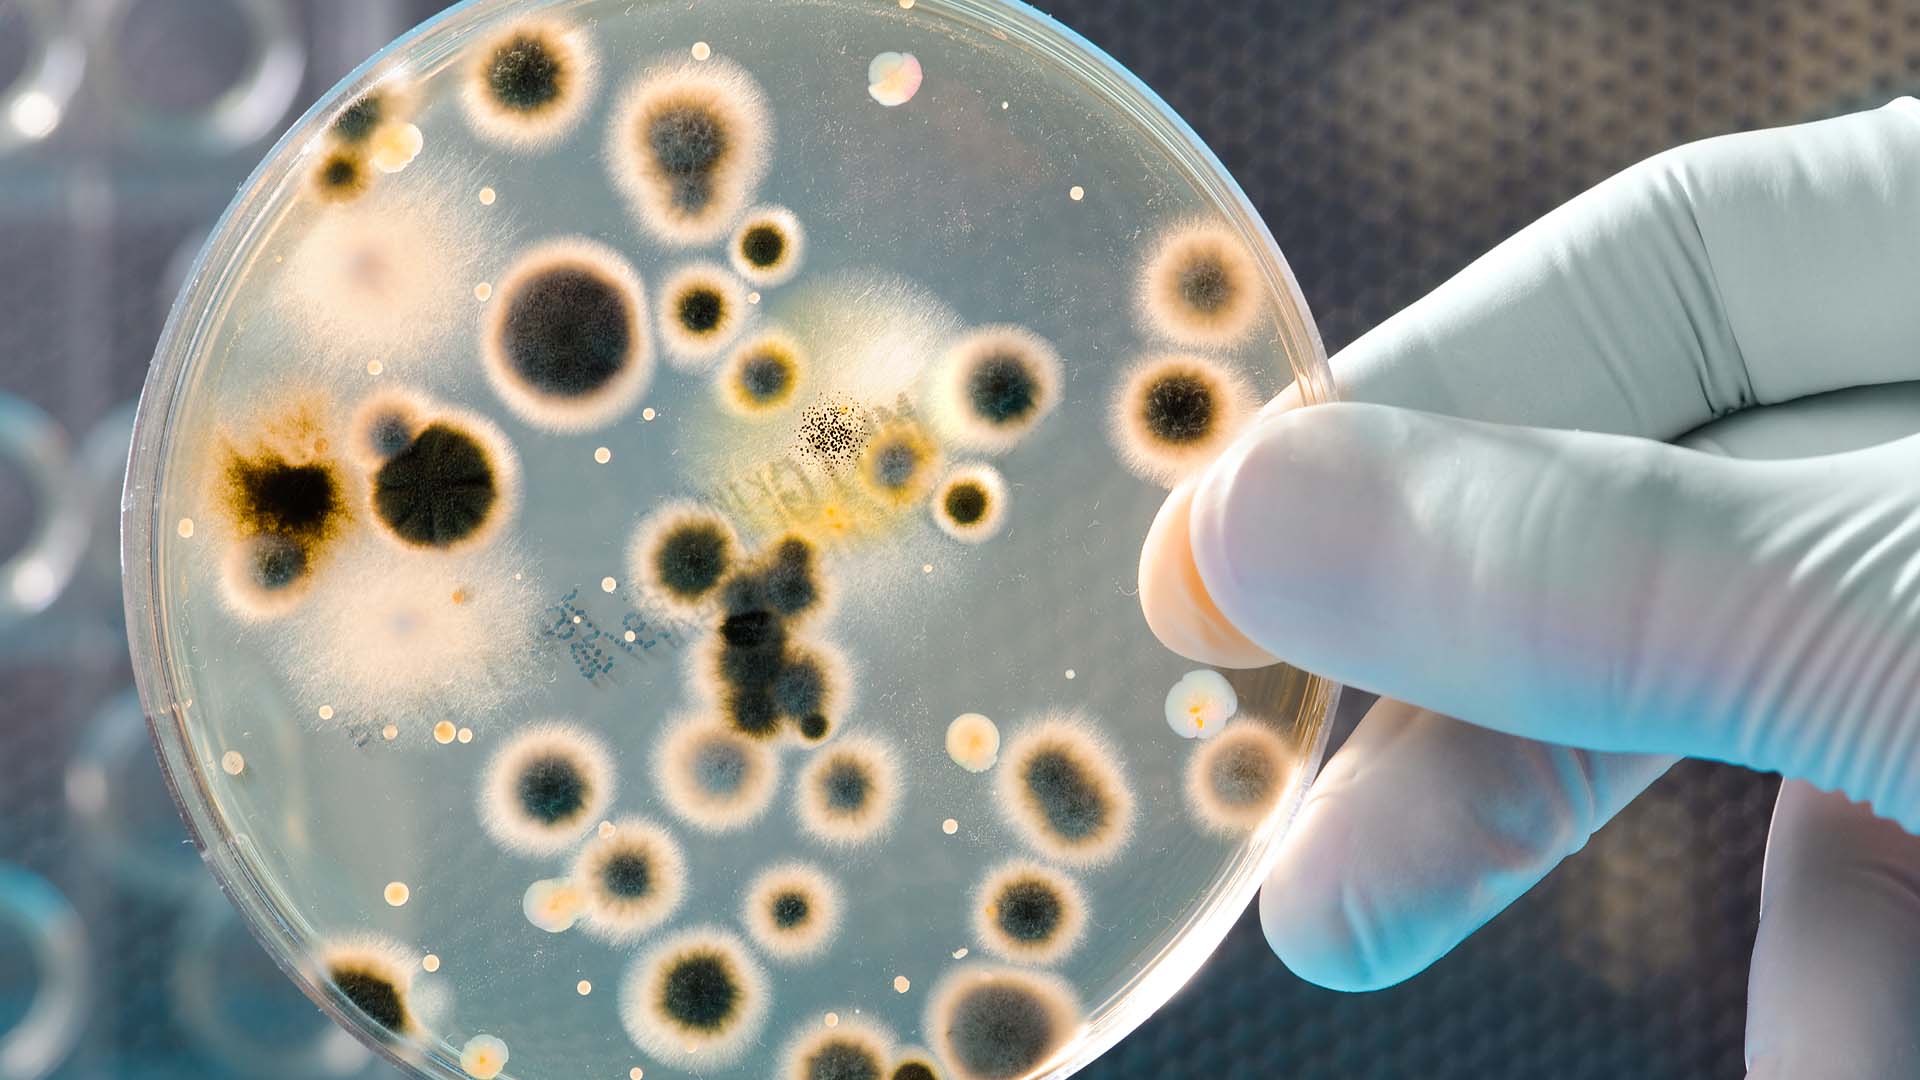

CONSULTANCY SERVICES
The term “Forensic” can be defined as “of, or relating to, the courts of law”. It comes from the Latin “forensis”, which is translated as forum.
A forensic investigation is an investigation that is relevant to and may be used in a court of law, and therefore any investigative work that is done to a forensic standard must be carried out to a high enough standard that it may be presented in a court of law. This involves ensuring that:
- All personnel involved are properly trained and qualified.
- All work performed is properly recorded with photographs as may be required.
- Any samples taken, analysed or tested are traceable and that a chain of custody can be established.
- All work is carried out diligently.
- There are proper records of the calibration and suitability of any equipment and consumables utilised.
- There is no question as to the integrity of the work or personnel carrying out the investigation.
- As a result there is complete confidence in the results of any investigation.
The majority of our consultants are experienced Expert Witnesses who have spent many hours giving evidence in court or arbitration both in the UK and abroad. Minton, Treharne & Davies Ltd. is represented in the Directory of Expert Witnesses, the Bureau of Arson Investigators, the Academy of Experts, the UK Register of Expert Witnesses, the Forensic Science Society and the Register of Forensic Practitioners.
For more information about our Consultancy services get in touch.